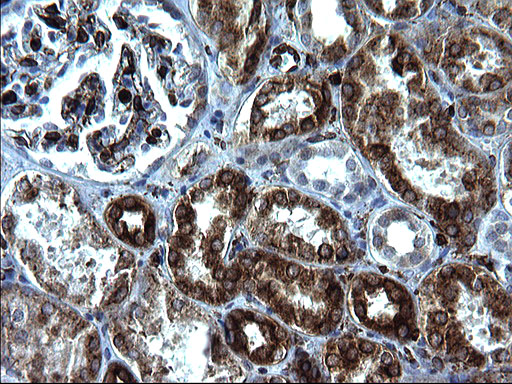
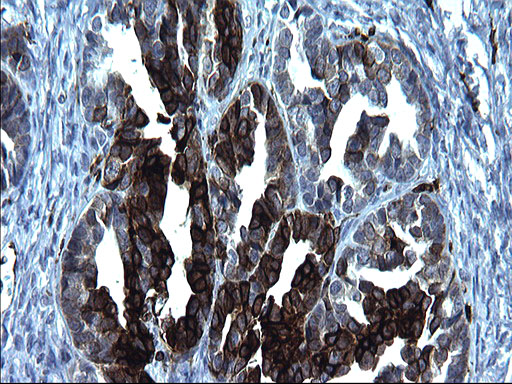

| Western blot (WB): | 1:4000 |
| Immunohistochemistry (IHC): | 1:150 |

Immunohistochemical staining of paraffin-embedded Human endometrium tissue within the normal limits using anti-CD74 mouse monoclonal antibody. (Heat-induced epitope retrieval by 1mM EDTA in 10mM Tris, pH8.5, 120°C for 3min, M01340-3)

Immunohistochemical staining of paraffin-embedded Human Kidney tissue within the normal limits using anti-CD74 mouse monoclonal antibody. (Heat-induced epitope retrieval by 1mM EDTA in 10mM Tris, pH8.5, 120°C for 3min, M01340-3)

Immunohistochemical staining of paraffin-embedded Adenocarcinoma of Human ovary tissue using anti-CD74 mouse monoclonal antibody. (Heat-induced epitope retrieval by 1mM EDTA in 10mM Tris, pH8.5, 120°C for 3min, M01340-3)

Immunohistochemical staining of paraffin-embedded Human lymph node tissue within the normal limits using anti-CD74 mouse monoclonal antibody. (Heat-induced epitope retrieval by 1mM EDTA in 10mM Tris, pH8.5, 120°C for 3min, M01340-3)

HEK293T cells were transfected with the pCMV6-ENTRY control (Left lane) or pCMV6-ENTRY CD74 (Right lane) cDNA for 48 hrs and lysed. Equivalent amounts of cell lysates (5 ug per lane) were separated by SDS-PAGE and immunoblotted with anti-CD74.

Immunohistochemical staining of paraffin-embedded Human endometrium tissue within the normal limits using anti-CD74 mouse monoclonal antibody. (Heat-induced epitope retrieval by 1mM EDTA in 10mM Tris, pH8.5, 120°C for 3min, M01340-3)

Immunohistochemical staining of paraffin-embedded Human Kidney tissue within the normal limits using anti-CD74 mouse monoclonal antibody. (Heat-induced epitope retrieval by 1mM EDTA in 10mM Tris, pH8.5, 120°C for 3min, M01340-3)

Immunohistochemical staining of paraffin-embedded Adenocarcinoma of Human ovary tissue using anti-CD74 mouse monoclonal antibody. (Heat-induced epitope retrieval by 1mM EDTA in 10mM Tris, pH8.5, 120°C for 3min, M01340-3)

Immunohistochemical staining of paraffin-embedded Human lymph node tissue within the normal limits using anti-CD74 mouse monoclonal antibody. (Heat-induced epitope retrieval by 1mM EDTA in 10mM Tris, pH8.5, 120°C for 3min, M01340-3)

HEK293T cells were transfected with the pCMV6-ENTRY control (Left lane) or pCMV6-ENTRY CD74 (Right lane) cDNA for 48 hrs and lysed. Equivalent amounts of cell lysates (5 ug per lane) were separated by SDS-PAGE and immunoblotted with anti-CD74.